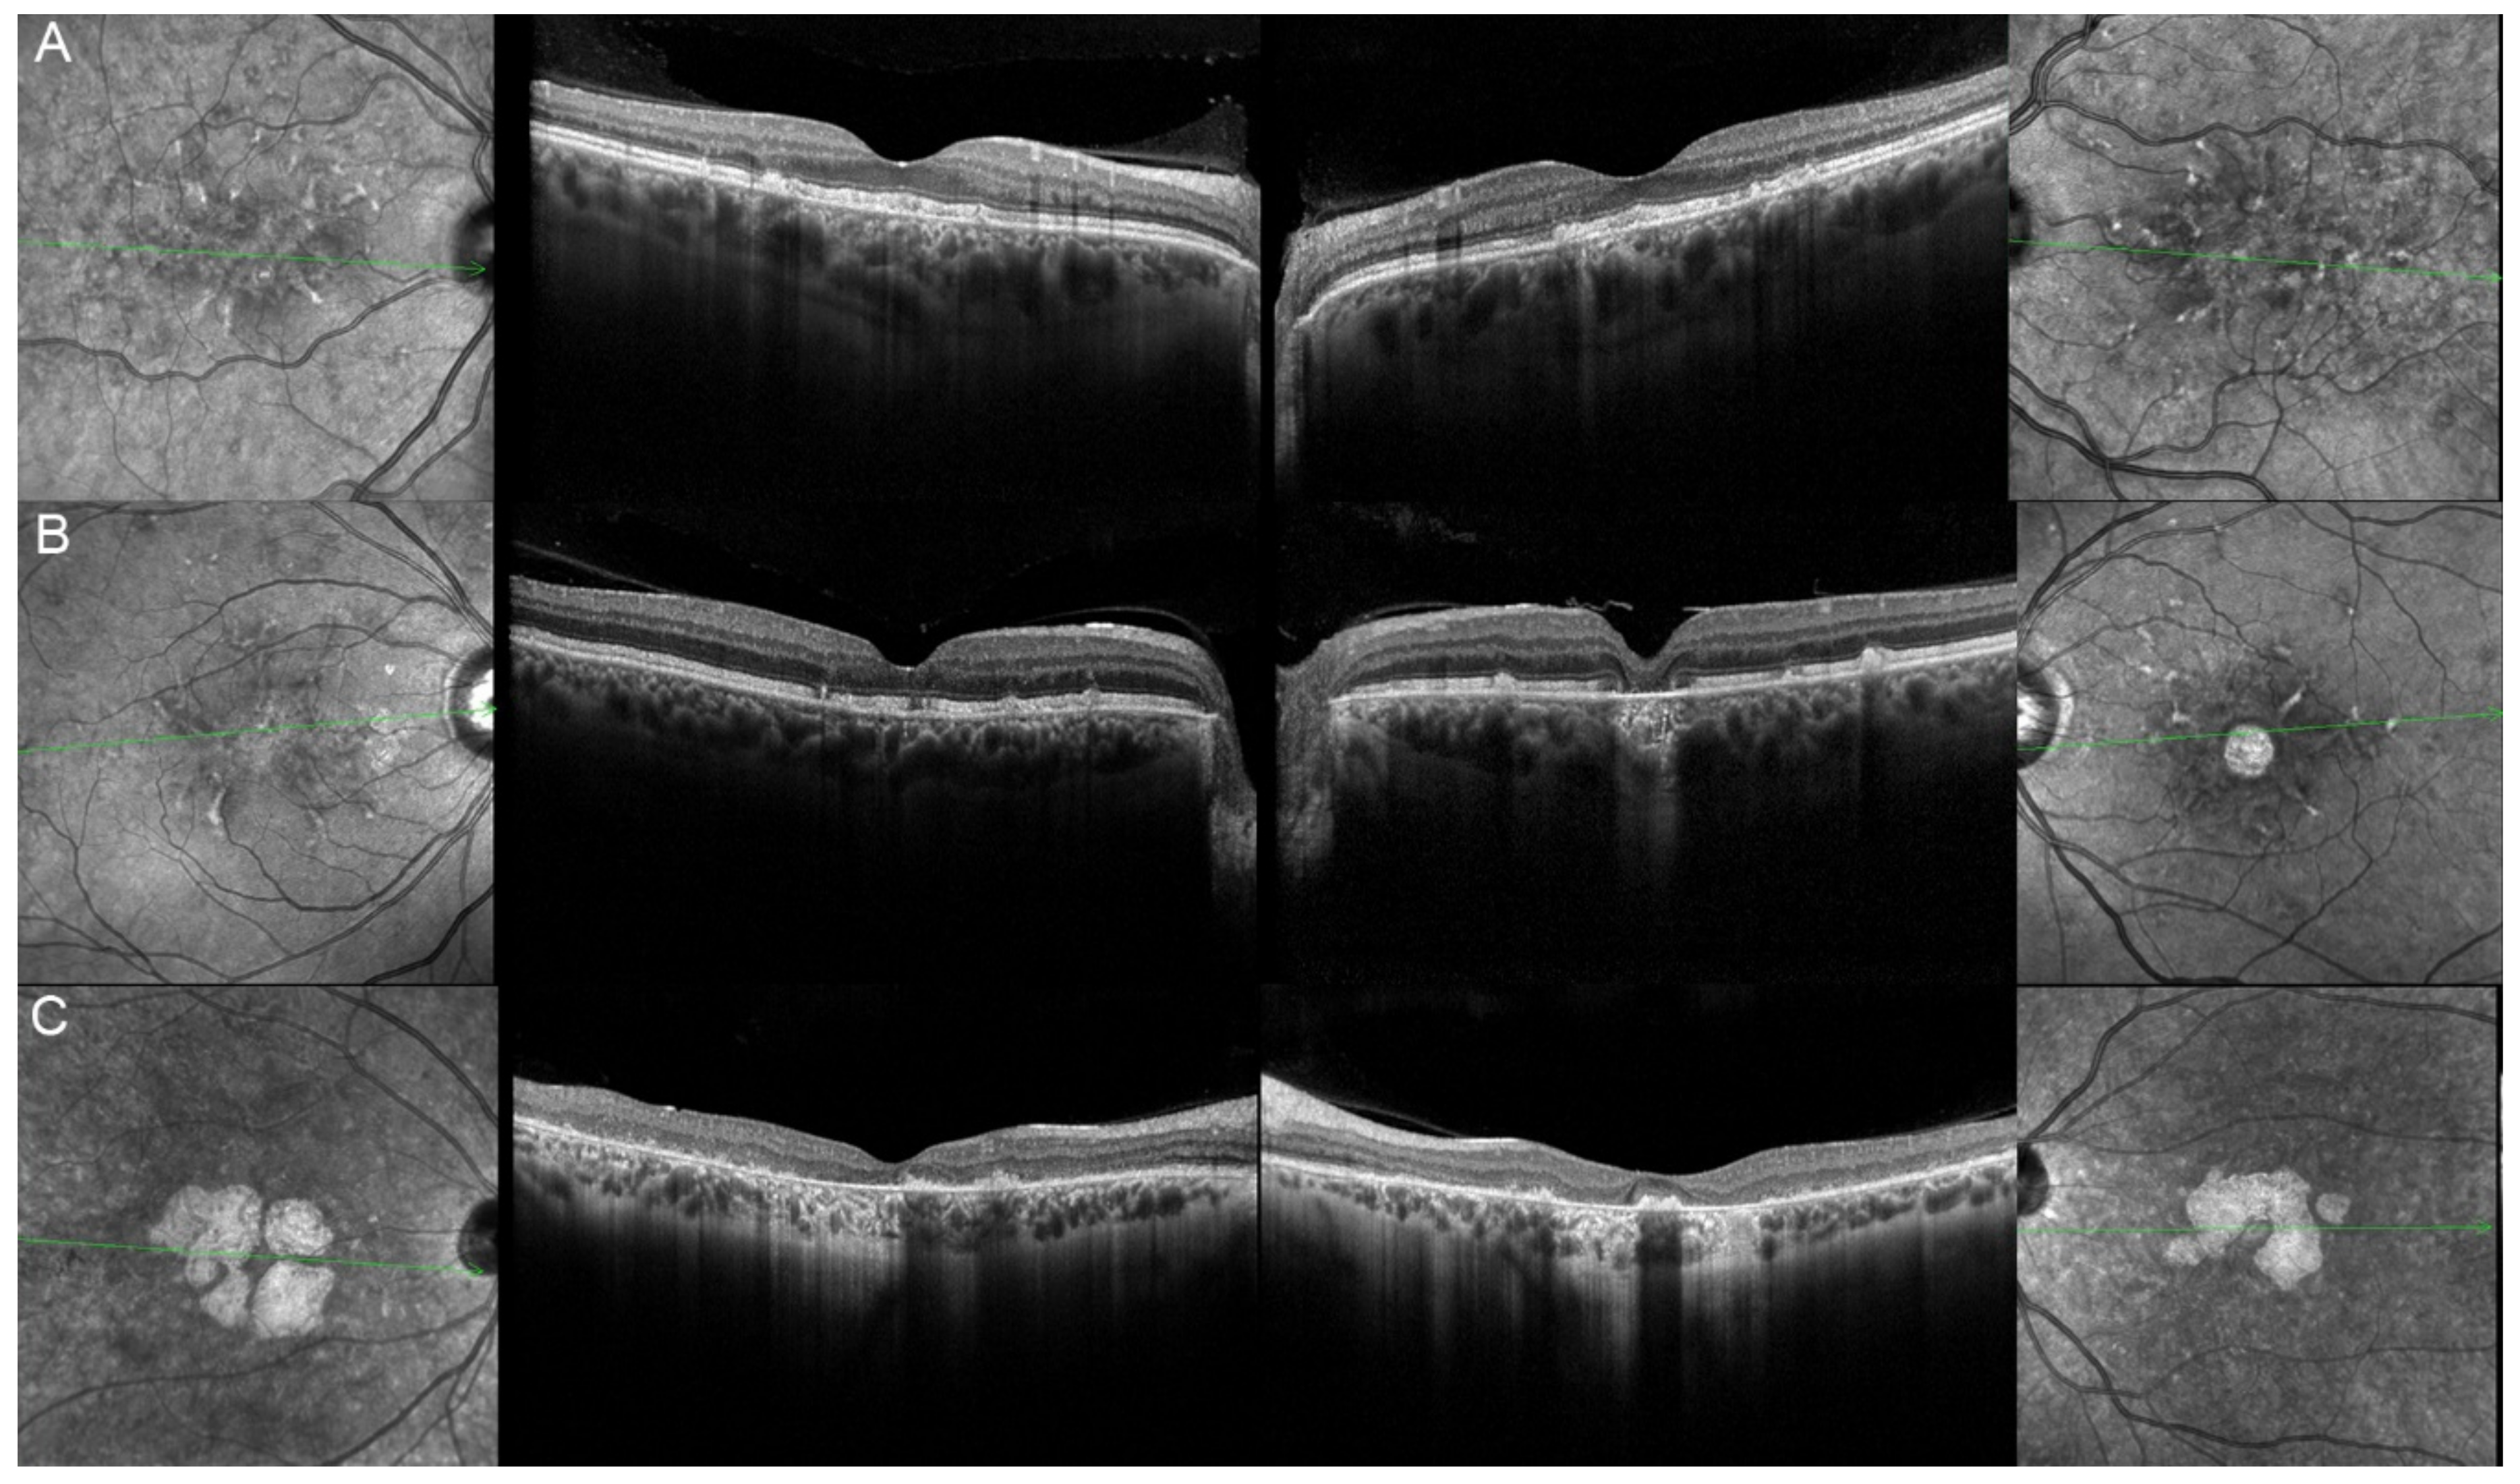
Genes 12 00812 g012 Genes 12 00812 g012

Absence of Genotype/Phenotype Correlations Requires Molecular Diagnostic to Ascertain Stargardt and Stargardt-Like Swiss Patients
Abstract
1. Introduction
2. Materials and Methods
2.1. Patients
2.2. Molecular Genetic Analysis
2.3. Clinical Data
3. Results
4. Discussion
5. Conclusions
Author Contributions
Funding
Acknowledgments
Conflicts of Interest
References
- Tanna, P.; Strauss, R.W.; Fujinami, K.; Michaelides, M. Stargardt disease: Clinical features, molecular genetics, animal models and therapeutic options. Br. J. Ophthalmol. 2016, 101, 25–30. [Google Scholar] [CrossRef]
- Rahman, N.; Georgiou, M.; Khan, K.N.; Michaelides, M. Macular dystrophies: Clinical and imaging features, molecular genetics and therapeutic options. Br. J. Ophthalmol. 2019, 104, 451–460. [Google Scholar] [CrossRef]
- Fujinami, K.; Zernant, J.; Chana, R.K.; Wright, G.A.; Tsunoda, K.; Ozawa, Y.; Tsubota, K.; Robson, A.; Holder, G.E.; Allikmets, R.; et al. Clinical and Molecular Characteristics of Childhood-Onset Stargardt Disease. Ophthalmology 2015, 122, 326–334. [Google Scholar] [CrossRef]
- Haaften, S.C.W.-V.; Boon, C.J.; Cremers, F.P.; Hoefsloot, L.H.; Hollander, A.I.D.; Hoyng, C.B. Clinical and Genetic Characteristics of Late-onset Stargardt’s Disease. Ophthalmology 2012, 119, 1199–1210. [Google Scholar] [CrossRef]
- Cremers, F.P.M.; Van De Pol, D.J.R.; Van Driel, M.; Hollander, A.I.D.; Van Haren, F.J.J.; Knoers, N.V.A.M.; Tijmes, N.; Bergen, A.A.B.; Rohrschneider, K.; Blankenagel, A.; et al. Autosomal recessive retinitis pigmentosa and cone-rod dystrophy caused by splice site mutations in the Stargardt’s disease gene ABCR. Hum. Mol. Genet. 1998, 7, 355–362. [Google Scholar] [CrossRef] [PubMed]
- Martínez-Mir, A.; Paloma, E.; Allikmets, R.; Ayuso, C.; Del Río, T.; Dean, M.; Vilageliu, L.; Gonzàlez-Duarte, R.; Balcells, S. Retinitis pigmentosa caused by a homozygous mutation in the Stargardt disease gene ABCR. Nat. Genet. 1998, 18, 11–12. [Google Scholar] [CrossRef] [PubMed]
- Cicinelli, M.V.; Battista, M.; Starace, V.; Parodi, M.B.; Bandello, F. Monitoring and Management of the Patient with Stargardt Disease. Clin. Optom. 2019, 11, 151–165. [Google Scholar] [CrossRef]
- Cornelis, S.S.; Bax, N.M.; Zernant, J.; Allikmets, R.; Fritsche, L.G.; Dunnen, J.T.D.; Ajmal, M.; Hoyng, C.B.; Cremers, F.P. In Silico Functional Meta-Analysis of 5,962 ABCA4 Variants in 3,928 Retinal Dystrophy Cases. Hum. Mutat. 2017, 38, 400–408. [Google Scholar] [CrossRef] [PubMed]
- Fujinami, K.; Sergouniotis, P.I.; Davidson, A.E.; Mackay, D.; Tsunoda, K.; Tsubota, K.; Robson, A.; Holder, G.E.; Moore, A.T.; Michaelides, M.; et al. The Clinical Effect of Homozygous ABCA4 Alleles in 18 Patients. Ophthalmology 2013, 120, 2324–2331. [Google Scholar] [CrossRef]
- Sangermano, R.; Khan, M.; Cornelis, S.S.; Richelle, V.; Albert, S.; Garanto, A.; Elmelik, D.; Qamar, R.; Lugtenberg, D.; Born, L.I.V.D.; et al. ABCA4 midigenes reveal the full splice spectrum of all reported noncanonical splice site variants in Stargardt disease. Genome Res. 2017, 28, 100–110. [Google Scholar] [CrossRef]
- Sangermano, R.; Garanto, A.; Khan, M.; Runhart, E.H.; Bauwens, M.; Bax, N.M.; Born, L.I.V.D.; Khan, M.I.; Msc, S.S.C.; Verheij, J.B.G.M.; et al. Deep-intronic ABCA4 variants explain missing heritability in Stargardt disease and allow correction of splice defects by antisense oligonucleotides. Genet. Med. 2019, 21, 1751–1760. [Google Scholar] [CrossRef]
- Burke, T.R.; Fishman, G.A.; Zernant, J.; Schubert, C.; Tsang, S.H.; Smith, R.T.; Ayyagari, R.; Koenekoop, R.K.; Umfress, A.; Ciccarelli, M.L.; et al. Retinal Phenotypes in Patients Homozygous for the G1961E Mutation in theABCA4Gene. Investig. Opthalmology Vis. Sci. 2012, 53, 4458–4467. [Google Scholar] [CrossRef]
- Zhang, K.; Kniazeva, M.; Han, M.; Li, W.; Yu, Z.; Yang, Z.; Li, Y.; Metzker, M.L.; Allikmets, R.; Zack, D.J.; et al. A 5-bp deletion in ELOVL4 is associated with two related forms of autosomal dominant macular dystrophy. Nat. Genet. 2001, 27, 89–93. [Google Scholar] [CrossRef]
- Palejwala, N.V.; Gale, M.J.; Clark, R.F.; Schlechter, C.; Weleber, R.G.; Pennesi, M.E. Insights into autosomal dominant stargardt-like macular dystrophy through multimodality diagnostic imaging. Retina 2016, 36, 119–130. [Google Scholar] [CrossRef]
- Yang, Z.; Chen, Y.; Lillo, C.; Chien, J.; Yu, Z.; Michaelides, M.; Klein, M.; Howes, K.A.; Li, Y.; Kaminoh, Y.; et al. Mutant prominin 1 found in patients with macular degeneration disrupts photoreceptor disk morphogenesis in mice. J. Clin. Investig. 2008, 118, 2908–2916. [Google Scholar] [CrossRef]
- Yang, Z.; Li, Y.; Jiang, L.; Karan, G.; Moshfeghi, D.; O’Connor, S.; Li, X.; Yu, Z.; Lewis, H.; Zack, D.; et al. A novel RDS/peripherin gene mutation associated with diverse macular phenotypes. Ophthalmic Genet. 2004, 25, 133–145. [Google Scholar] [CrossRef]
- Yeboah, G.K.; Lobanova, E.S.; Brush, R.S.; Agbaga, M.-P. Very long chain fatty acid-containing lipids: A decade of novel insights from the study of ELOVL4. J. Lipid Res. 2021, 62, 100030. [Google Scholar] [CrossRef] [PubMed]
- Maugeri, A.; Meire, F.; Hoyng, C.B.; Vink, C.; Van Regemorter, N.; Karan, G.; Yang, Z.; Cremers, F.P.M.; Zhang, K. A Novel Mutation in theELOVL4Gene Causes Autosomal Dominant Stargardt-like Macular Dystrophy. Investig. Ophthalmol. Vis. Sci. 2004, 45, 4263–4267. [Google Scholar] [CrossRef] [PubMed]
- Vasireddy, V.; Wong, P.; Ayyagari, R. Genetics and molecular pathology of Stargardt-like macular degeneration. Prog. Retin. Eye Res. 2010, 29, 191–207. [Google Scholar] [CrossRef] [PubMed]
- Vaclavik, V.; Tran, H.V.; Gaillard, M.-C.; Schorderet, D.F.; Munier, F.L. Pattern dystrophy with high intrafamilial variability associated with y141c mutation in the peripherin/rds gene and successful treatment of subfoveal cnv related to multifocal pattern type with anti-vegf (ranibizumab) intravitreal injections. Retina 2012, 32, 1942–1949. [Google Scholar] [CrossRef] [PubMed]
- Stuck, M.W.; Conley, S.M.; Naash, M.I. Retinal Degeneration Slow (RDS) Glycosylation Plays a Role in Cone Function and in the Regulation of RDS·ROM-1 Protein Complex Formation. J. Biol. Chem. 2015, 290, 27901–27913. [Google Scholar] [CrossRef] [PubMed]
- Chakraborty, D.; Conley, S.M.; Al-Ubaidi, M.R.; Naash, M.I. Initiation of Rod Outer Segment Disc Formation Requires RDS. PLoS ONE 2014, 9, e98939. [Google Scholar] [CrossRef]
- Tebbe, L.; Kakakhel, M.; Makia, M.S.; Al-Ubaidi, M.R.; Naash, M.I. The Interplay between Peripherin 2 Complex Formation and Degenerative Retinal Diseases. Cells 2020, 9, 784. [Google Scholar] [CrossRef]
- Richards, S.; Aziz, N.; Bale, S.; Bick, D.; Das, S.; Gastier-Foster, J.; Grody, W.W.; Hegde, M.; Lyon, E.; Spector, E.; et al. Standards and guidelines for the interpretation of sequence variants: A joint consensus recommendation of the American College of Medical Genetics and Genomics and the Association for Molecular Pathology. Genet. Med. 2015, 17, 405–423. [Google Scholar] [CrossRef]
- Koyanagi, Y.; Akiyama, M.; Nishiguchi, K.M.; Momozawa, Y.; Kamatani, Y.; Takata, S.; Inai, C.; Iwasaki, Y.; Kumano, M.; Murakami, Y.; et al. Genetic characteristics of retinitis pigmentosa in 1204 Japanese patients. J. Med. Genet. 2019, 56, 662–670. [Google Scholar] [CrossRef]
- Stone, E.M.; Andorf, J.L.; Whitmore, S.S.; DeLuca, A.P.; Giacalone, J.C.; Streb, L.M.; Braun, T.A.; Mullins, R.F.; Scheetz, T.E.; Sheffield, V.C.; et al. Clinically Focused Molecular Investigation of 1000 Consecutive Families with Inherited Retinal Disease. Ophthalmology 2017, 124, 1314–1331. [Google Scholar] [CrossRef] [PubMed]
- Lewis, R.A.; Shroyer, N.F.; Singh, N.; Allikmets, R.; Hutchinson, A.; Li, Y.; Lupski, J.R.; Leppert, M.; Dean, M. Genotype/Phenotype Analysis of a Photoreceptor-Specific ATP-Binding Cassette Transporter Gene, ABCR, in Stargardt Disease. Am. J. Hum. Genet. 1999, 64, 422–434. [Google Scholar] [CrossRef] [PubMed]
- Rozet, J.-M.; Gerber, S.; Souied, E.; Perrault, I.; Châtelin, S.; Ghazi, I.; Leowski, C.; Dufier, J.-L.; Munnich, A.; Kaplan, J. Spectrum of ABCR gene mutations in autosomal recessive macular dystrophies. Eur. J. Hum. Genet. 1998, 6, 291–295. [Google Scholar] [CrossRef]
- Paloma, E.; Martínez-Mir, A.; Vilageliu, L.; Gonzàlez-Duarte, R.; Balcells, S. Spectrum ofABCA4(ABCR) gene mutations in Spanish patients with autosomal recessive macular dystrophies. Hum. Mutat. 2001, 17, 504–510. [Google Scholar] [CrossRef]
- Gerber, S.; Rozet, J.; Van De Pol, T.; Hoyng, C.; Munnich, A.; Blankenagel, A.; Kaplan, J.; Cremers, F. Complete Exon–Intron Structure of the Retina-Specific ATP Binding Transporter Gene (ABCR) Allows the Identification of Novel Mutations Underlying Stargardt Disease. Genomics 1998, 48, 139–142. [Google Scholar] [CrossRef]
- Maugeri, A.; van Driel, M.A.; van de Pol, D.J.; Klevering, B.J.; van Haren, F.J.; Tijmes, N.; Bergen, A.A.; Rohrschneider, K.; Blankenagel, A.; Pinckers, A.J.; et al. The 2588G→C Mutation in the ABCR Gene Is a Mild Frequent Founder Mutation in the Western European Population and Allows the Classification of ABCR Mutations in Patients with Stargardt Disease. Am. J. Hum. Genet. 1999, 64, 1024–1035. [Google Scholar] [CrossRef]
- Zernant, J.; Schubert, C.; Im, K.M.; Burke, T.; Brown, C.M.; Fishman, G.A.; Tsang, S.H.; Gouras, P.; Dean, M.; Allikmets, R. Analysis of theABCA4Gene by Next-Generation Sequencing. Investig. Ophthalmol. Vis. Sci. 2011, 52, 8479–8487. [Google Scholar] [CrossRef]
- Rivera, A.; White, K.; Stöhr, H.; Steiner, K.; Hemmrich, N.; Grimm, T.; Jurklies, B.; Lorenz, B.; Scholl, H.P.; Apfelstedt-Sylla, E.; et al. A Comprehensive Survey of Sequence Variation in the ABCA4 (ABCR) Gene in Stargardt Disease and Age-Related Macular Degeneration. Am. J. Hum. Genet. 2000, 67, 800–813. [Google Scholar] [CrossRef] [PubMed]
- Boulanger-Scemama, E.; El Shamieh, S.; Démontant, V.; Condroyer, C.; Antonio, A.; Michiels, C.; Boyard, F.; Saraiva, J.-P.; Letexier, M.; Souied, E.H.; et al. Next-generation sequencing applied to a large French cone and cone-rod dystrophy cohort: Mutation spectrum and new genotype-phenotype correlation. Orphanet J. Rare Dis. 2015, 10, 1–20. [Google Scholar] [CrossRef] [PubMed]
- Klevering, B.J.; Yzer, S.; Rohrschneider, K.; Zonneveld, M.; Allikmets, R.; Born, L.I.V.D.; Maugeri, A.; Hoyng, C.B.; Cremers, F.P. Microarray-based mutation analysis of the ABCA4 (ABCR) gene in autosomal recessive cone–rod dystrophy and retinitis pigmentosa. Eur. J. Hum. Genet. 2004, 12, 1024–1032. [Google Scholar] [CrossRef]
- Birtel, J.; Eisenberger, T.; Gliem, M.; Müller, P.L.; Herrmann, P.; Betz, C.; Zahnleiter, D.; Neuhaus, C.; Lenzner, S.; Holz, F.G.; et al. Clinical and genetic characteristics of 251 consecutive patients with macular and cone/cone-rod dystrophy. Sci. Rep. 2018, 8, 1–11. [Google Scholar] [CrossRef]
- Michaelides, M.; Gaillard, M.-C.; Escher, P.; Tiab, L.; Bedell, M.; Borruat, F.-X.; Barthelmes, D.; Carmona, R.; Zhang, K.; White, E.; et al. The PROM1 mutation p.R373C causes an autosomal dominant bull’s eyemaculopathy associated with rod, rod-cone, and macular dystrophy. Investig. Ophthalmol. Vis. Sci. 2010, 51, 4771–4780. [Google Scholar] [CrossRef]
- Barber, L.; Khodai, O.; Croley, T.; Lievens, C.; Montaquila, S.; Ziemanski, J.; McCart, M.; Lunacsek, O.; Burk, C.; Patel, V. Dry eye symptoms and impact on vision-related function across International Task Force guidelines severity levels in the United States. BMC Ophthalmol. 2018, 18, 260. [Google Scholar] [CrossRef]
- Chua, E.B.; Mitchell, P.; Cumming, R. Effects of cataract type and location on visual function: The Blue Mountains Eye Study. Eye 2004, 18, 765–772. [Google Scholar] [CrossRef]
- Boon, C.J.F.; Van Schooneveld, M.J.; Hollander, A.I.D.; Van Lith-Verhoeven, J.J.C.; Zonneveld-Vrieling, M.N.; Theelen, T.; Cremers, F.P.M.; Hoyng, C.B.; Klevering, B.J. Mutations in the peripherin/RDS gene are an important cause of multifocal pattern dystrophy simulating STGD1/fundus flavimaculatus. Br. J. Ophthalmol. 2007, 91, 1504–1511. [Google Scholar] [CrossRef]
- Bernstein, P.S.; Tammur, J.; Singh, N.; Hutchinson, A.; Dixon, M.; Pappas, C.M.; Zabriskie, A.N.; Zhang, K.; Petrukhin, K.; Leppert, M.; et al. Diverse macular dystrophy phenotype caused by a novel complex mutation in the ELOVL4 gene. Investig. Ophthalmol. Vis. Sci. 2001, 42, 3331–3336. [Google Scholar]
- Llavona, P.; Pinelli, M.; Mutarelli, M.; Marwah, V.S.; Schimpf-Linzenbold, S.; Thaler, S.; Yoeruek, E.; Vetter, J.; Kohl, S.; Wissinger, B. Allelic Expression Imbalance in the Human Retinal Transcriptome and Potential Impact on Inherited Retinal Diseases. Genes 2017, 8, 283. [Google Scholar] [CrossRef] [PubMed]
- Sparrow, J.R.; Duncker, T.; Schuerch, K.; Paavo, M.; De Carvalho, J.R.L. Lessons learned from quantitative fundus autofluorescence. Prog. Retin. Eye Res. 2020, 74, 100774. [Google Scholar] [CrossRef] [PubMed]
- Duncker, T.; Tsang, S.H.; Woods, R.; Lee, W.; Zernant, J.; Allikmets, R.; Delori, F.C.; Sparrow, J.R. Quantitative Fundus Autofluorescence and Optical Coherence Tomography inPRPH2/RDS- andABCA4-Associated Disease Exhibiting Phenotypic Overlap. Investig. Ophthalmol. Vis. Sci. 2015, 56, 3159–3170. [Google Scholar] [CrossRef] [PubMed]
- Gliem, M.; Müller, P.L.; Birtel, J.; Herrmann, P.; McGuinness, M.B.; Holz, F.G.; Issa, P.C. Quantitative Fundus Autofluorescence and Genetic Associations in Macular, Cone, and Cone–Rod Dystrophies. Ophthalmol. Retin. 2020, 4, 737–749. [Google Scholar] [CrossRef] [PubMed]
- Radu, R.A.; Yuan, Q.; Hu, J.; Peng, J.H.; Lloyd, M.; Nusinowitz, S.; Bok, D.; Travis, G.H. Accelerated Accumulation of Lipofuscin Pigments in the RPE of a Mouse Model forABCA4-Mediated Retinal Dystrophies following Vitamin A Supplementation. Investig. Ophthalmol. Vis. Sci. 2008, 49, 3821–3829. [Google Scholar] [CrossRef]

| Family/ patient | Gene | Variants | Zygosity | Pathogenicity | First Description |
|---|---|---|---|---|---|
| 1/II.2 | ABCA4 | c.673G>A p.(Val225Met) | heterozygous | likely pathogenic | [25] |
| c.6119G>A p.(Arg2040Gln) | heterozygous | pathogenic | [4] | ||
| 2/II.1 | ABCA4 | c.1760+2T>C p.? | heterozygous | pathogenic | novel |
| c.3727T>G p.(Tyr1243Asp) | heterozygous | likely pathogenic | [25] | ||
| 3/II.2 | ABCA4 | c.4124C>A p.(Ala1375Glu) | heterozygous | likely pathogenic | [26] |
| c.5377G>A p.(Val1793Met) | heterozygous | likely pathogenic | [26] | ||
| 4/II.2 | ABCA4 | c.3322C>T p.(Arg1108Cys) | heterozygous | pathogenic | [27] |
| c.5882G>A p.(Gly1961Glu) | heterozygous | pathogenic | [27] | ||
| c.6320G>A p.(Arg2107His) | heterozygous | VUS | [28] | ||
| 5/II.2 | ABCA4 | c.3758C>T p.(Thr1253Met) | heterozygous | likely pathogenic | [29] |
| c.5882G>A p.(Gly1961Glu) | heterozygous | pathogenic | [27] | ||
| 6/II.2 | ABCA4 | c.634C>T p.(Arg212Cys) | heterozygous | pathogenic | [30] |
| c.5882G>A p.(Gly1961Glu) | heterozygous | pathogenic | [27] | ||
| 7/II.1 | ABCA4 | c.1622T>C p.(Leu541Pro) | heterozygous | likely pathogenic | [27] |
| c.2588G>C p.[(Gly863Ala,Gly863del)] | heterozygous | likely pathogenic | [31] | ||
| c.3113C>T p.(Ala1038Val) | heterozygous | pathogenic | [27] | ||
| 8/III.2 | ABCA4 | c.2401G>A p.(Ala801Thr) | heterozygous | likely pathogenic | [32] |
| c.5018+2T>C p.? | heterozygous | pathogenic | [33] | ||
| 9/II.2 | ABCA4 | c.1804C>T p.(Arg602Trp) | heterozygous | pathogenic | [27] |
| c.5882G>A p.(Gly1961Glu) | heterozygous | pathogenic | [27] | ||
| 10/I.2 | ABCA4 | c.1302delA p.(Gln437Argfs*12) | heterozygous | pathogenic | [34] |
| c.4297G>A p.(Val1433Ile) | heterozygous | likely pathogenic | [35] | ||
| 11/III.1 | ABCA4 | c.1807T>C p.(Tyr603His) | heterozygous | likely pathogenic | [36] |
| c.4496T>C p.(Leu1499Pro) | heterozygous | likely pathogenic | novel | ||
| 12/II.2 | ELOVL4 | c.810C>G p.(Tyr270*) | heterozygous | pathogenic | [13] |
| 13/II.1 | ELOVL4 | c.810C>G p.(Tyr270*) | heterozygous | pathogenic | [13] |
| 13/III.2 | ELOVL4 | c.810C>G p.(Tyr270*) | heterozygous | pathogenic | [13] |
| 13/III.1 | ELOVL4 | c.810C>G p.(Tyr270*) | heterozygous | pathogenic | [13] |
| 13/I.1 | ELOVL4 | c.810C>G p.(Tyr270*) | heterozygous | pathogenic | [13] |
| 14/II.4 | ELOVL4 | c.810C>G, p.(Tyr270*) | heterozygous | pathogenic | [13] |
| 15/II.3 | ELOVL4 | c.810C>G p.(Tyr270*) | heterozygous | pathogenic | [13] |
| 16/III.2 | ELOVL4 | c.810C>G p.(Tyr270*) | heterozygous | pathogenic | [13] |
| 17/II.1 | PRPH2 | c.422A>G p.(Tyr141Cys) | heterozygous | pathogenic | [16] |
| 18/II.2 | PRPH2 | c.422A>G p.(Tyr141Cys) | heterozygous | pathogenic | [16] |
| 19/III.2 | PRPH2 | c.422A>G p.(Tyr141Cys) | heterozygous | pathogenic | [16] |
| Patient | Gene | Age | Sex | FAF | OCT |
|---|---|---|---|---|---|
| 1, II.2 | ABCA4 | 53 | F | Foveal HPAF | Subretinal hyperreflective deposits |
| 2, II.1 | ABCA4 | 18 | F | Central HOAF; concentric ring of HPAF | Central EZ disruption with gap; ONL atrophy |
| 3, II.2 | ABCA4 | 18 | F | Foveal HOAF; central mottled pattern of HPAF and HOAF flecks | Central EZ loss; central ONL atrophy |
| 4, II.2 | ABCA4 | 27 | F | Foveal HPAF; parafoveal HOAF; paramacular HPAF | Central EZ loss; central ONL atrophy |
| 5, II.2 | ABCA4 | 69 | F | Mid-peripheral mottled HOAF | Mid-peripheral ONL atrophy, lamellar macular hole (OD) |
| 6, II.2 | ABCA4 | 53 | F | Foveal HOAF; central mottled pattern of HPAF and HOAF flecks | Central EZ disruption with gap (OS) and loss (OD); central ONL atrophy |
| 7, II.1 | ABCA4 | 19 | F | Central HOAF; HPAF flecks | Central EZ loss; central ONL atrophy |
| 8, III.2 | ABCA4 | 30 | M | Central HOAF; HPAF flecks | NA |
| 9, II.2 | ABCA4 | 44 | F | Central mottled pattern of HPAF and HOAF flecks | Central EZ loss; central ONL atrophy |
| 10, I.2 | ABCA4 | 51 | F | Foveal HOAF; central mottled pattern of HPAF and HOAF flecks | Perifoveal EZ loss; perifoveal ONL atrophy; loss of the foveal depression |
| 11, III.1 | ABCA4 | 53 | M | Extended central and peripheral HOAF; panretinal diffuse mottled pattern of HPAF and HOAF flecks | ONL atrophy; peripheral choroidal atrophy; RPE atrophy; subretinal hyperreflective deposits |
| 12, II.2 | ELOVL4 | 37 | F | Central HOAF; concentric ring of HPAF | Central EZ loss; central ONL atrophy and RPE atrophy |
| 13, II.1 | ELOVL4 | 46 | F | Multifocal areolar parafoveal HOAF; mottled pattern of HPAF and HOAF flecks; perimacular to mid-peripheral HPAF flecks | Perimacular EZ loss; perimacular ONL atrophy; subretinal hyperreflective deposits |
| 13, III.2 | ELOVL4 | 19 | F | No special features | Subfoveal hyperreflective deposits (OD) |
| 13, III.1 | ELOVL4 | 21 | M | NA | No special features |
| 13, I.1 | ELOVL4 | 82 | M | Areolar HOAF; paracentral mottled pattern of HPAF and HOAF flecks | ONL thinning; perimacular localised EZ loss (OS) |
| 14, II.4 | ELOVL4 | 48 | M | Central mottled pattern of HPAF and HOAF flecks | Central EZ loss; central ONL atrophy; perimacular subretinal hyperreflective deposits |
| 15, II.3 | ELOVL4 | 34 | M | Subfoveal HOAF; concentric ring of HPAF | Central EZ disruption with gap; central ONL atrophy |
| 16, III.2 | ELOVL4 | 28 | F | NA | NA |
| 17, II.1 | PRPH2 | 51 | F | Butterfly pattern of HPAF and HOAF flecks; paramacular to mid-peripheral HPAF flecks | Irregular EZ thickening |
| 18, II.2 | PRPH2 | 69 | M | Subfoveal HOAF (OS); butterfly pattern of HPAF and HOAF flecks; paramacular to mid-peripheral HPAF flecks | Central EZ loss (OS); central ONL atrophy (OS); localised ONL thinning (OD) |
| 19, III.2 | PRPH2 | 39 | F | Central areolar HOAF; disseminated nummular HPAF | Extended retinal atrophy |
Publisher’s Note: MDPI stays neutral with regard to jurisdictional claims in published maps and institutional affiliations. |
© 2021 by the authors. Licensee MDPI, Basel, Switzerland. This article is an open access article distributed under the terms and conditions of the Creative Commons Attribution (CC BY) license (https://creativecommons.org/licenses/by/4.0/).
Share and Cite
Buhler, V.M.M.; Berger, L.; Schaller, A.; Zinkernagel, M.S.; Wolf, S.; Escher, P. Absence of Genotype/Phenotype Correlations Requires Molecular Diagnostic to Ascertain Stargardt and Stargardt-Like Swiss Patients. Genes 2021, 12, 812. https://doi.org/10.3390/genes12060812
Buhler VMM, Berger L, Schaller A, Zinkernagel MS, Wolf S, Escher P. Absence of Genotype/Phenotype Correlations Requires Molecular Diagnostic to Ascertain Stargardt and Stargardt-Like Swiss Patients. Genes. 2021; 12(6):812. https://doi.org/10.3390/genes12060812
Chicago/Turabian StyleBuhler, Virginie M.M., Lieselotte Berger, André Schaller, Martin S. Zinkernagel, Sebastian Wolf, and Pascal Escher. 2021. "Absence of Genotype/Phenotype Correlations Requires Molecular Diagnostic to Ascertain Stargardt and Stargardt-Like Swiss Patients" Genes 12, no. 6: 812. https://doi.org/10.3390/genes12060812
APA StyleBuhler, V. M. M., Berger, L., Schaller, A., Zinkernagel, M. S., Wolf, S., & Escher, P. (2021). Absence of Genotype/Phenotype Correlations Requires Molecular Diagnostic to Ascertain Stargardt and Stargardt-Like Swiss Patients. Genes, 12(6), 812. https://doi.org/10.3390/genes12060812






